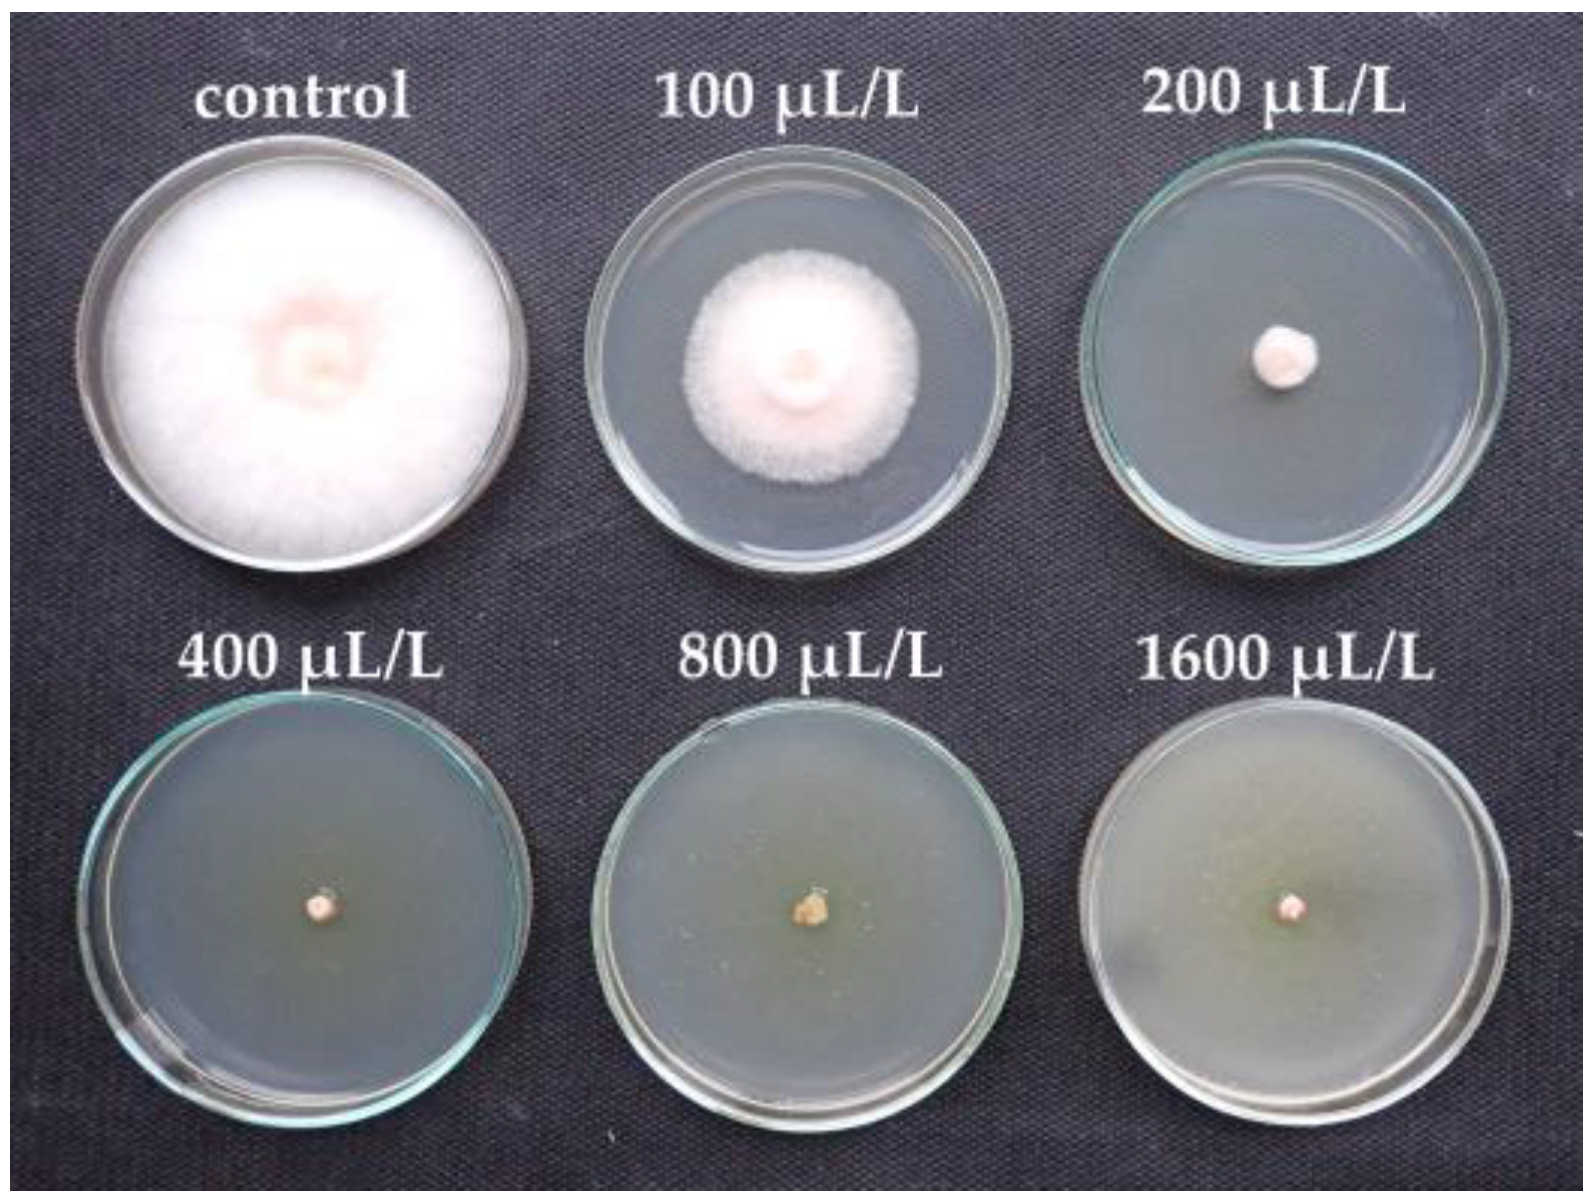
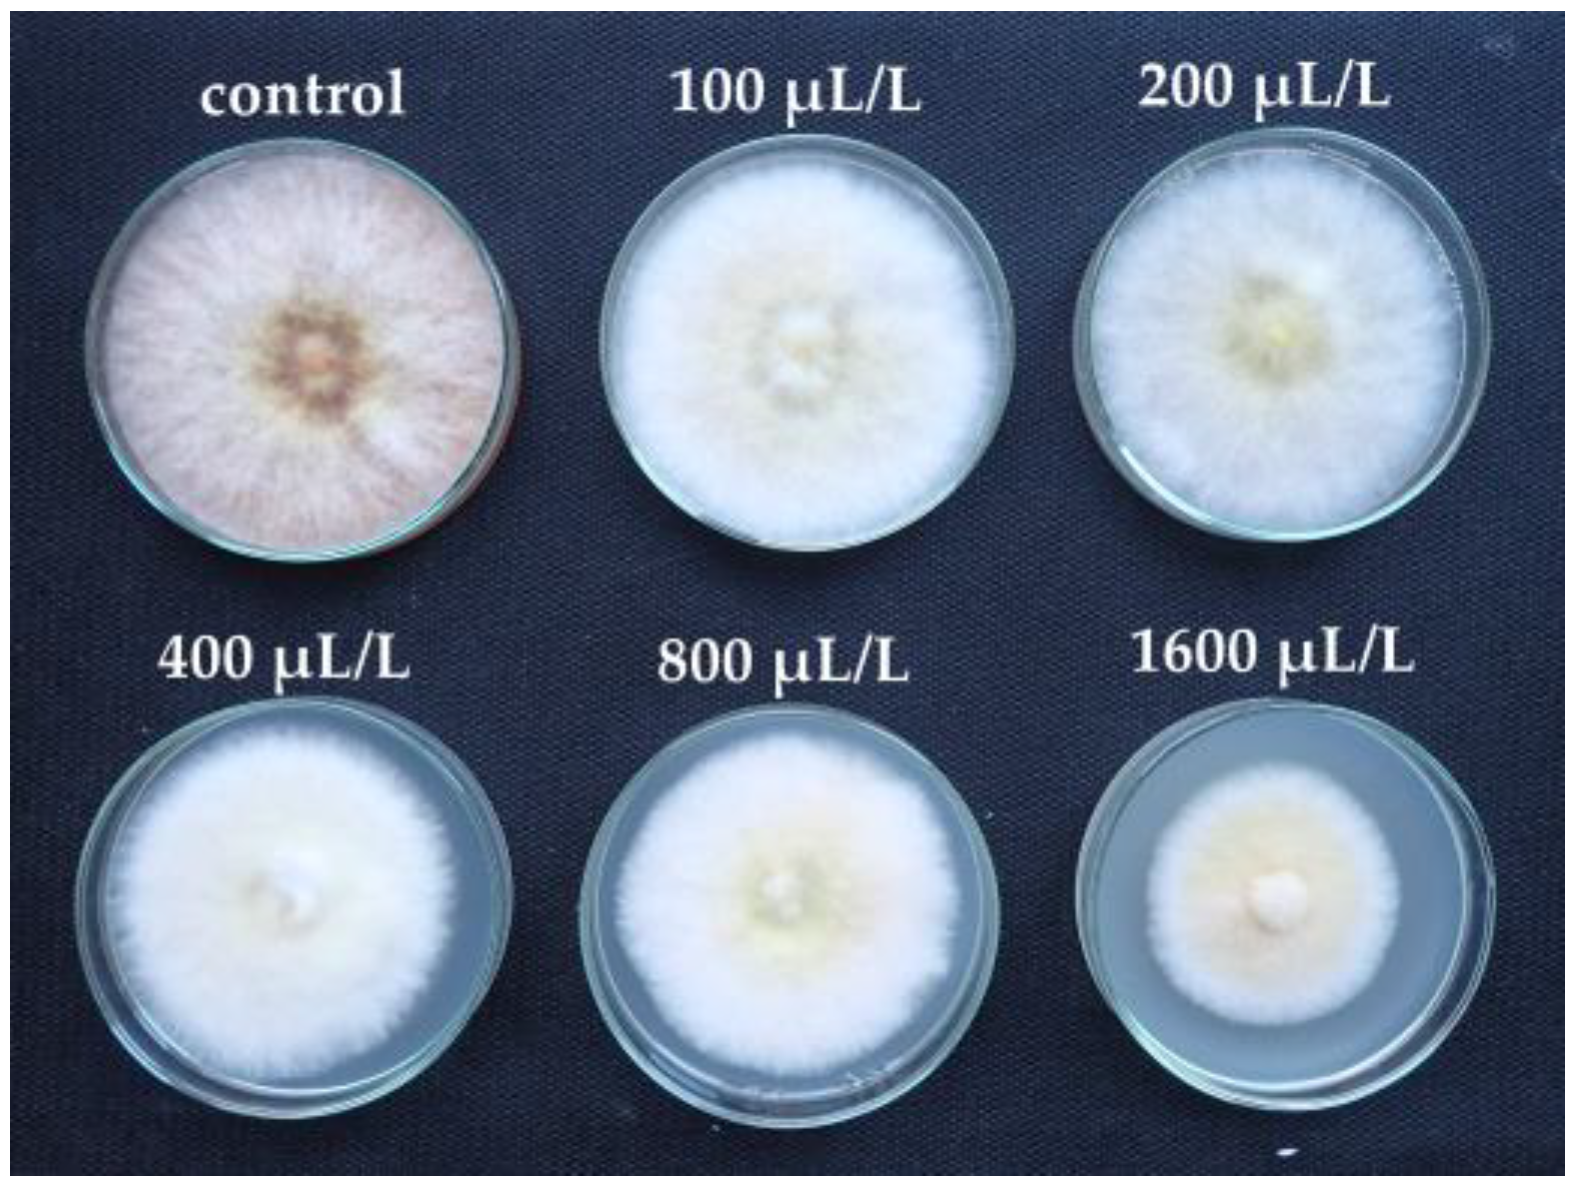

Effect of Essential Oil Components on the Growth Inhibition of Fusarium solani var. coeruleum During Potato Storage
Abstract
1. Introduction
2. Materials and Methods
2.1. Pathogen Culture and Inoculum Preparation
2.2. The Used EO Components
2.3. In Vitro Assays of the Antifungal Activity of EO Components
2.4. Assays of the Antifungal Activity of EO Components During Potato Storage
2.5. Organoleptic Test After EO Component Application by Dressing and Fumigation
2.6. Statistical Assessment of the Experiments
3. Results
3.1. In Vitro Antifungal Effect of EO Components
3.2. Antifungal Effect of EO Components During Potato Storage
3.3. Organoleptic Test After EO Component Application by Dressing and Fumigation
4. Discussion
5. Conclusions
Author Contributions
Funding
Data Availability Statement
Acknowledgments
Conflicts of Interest
References
- Cullen, D.W.; Toth, I.K.; Pitkin, Y.; Boonham, N.; Walsh, K.; Barker, I.; Lees, A.K. Use of Quantitative Molecular Diagnostic Assays to Investigate Fusarium Dry Rot in Potato Stocks and Soil. Phytopathology 2005, 95, 1462–1471. [Google Scholar] [CrossRef]
- Stevenson, W.R. (Ed.) Compendium of Potato Diseases, 2nd ed.; The Disease Compendia Series; American Phytopathological Society: St. Paul, MN, USA, 2001; ISBN 978-0-89054-275-0. [Google Scholar]
- Gachango, E.; Hanson, L.E.; Rojas, A.; Hao, J.J.; Kirk, W.W. Fusarium spp. Causing Dry Rot of Seed Potato Tubers in Michigan and Their Sensitivity to Fungicides. Plant Dis. 2012, 96, 1767–1774. [Google Scholar] [CrossRef]
- Estrada, R., Jr.; Gudmestad, N.C.; Rivera, V.V.; Secor, G.A. Fusarium graminearum as a Dry Rot Pathogen of Potato in the USA: Prevalence, Comparison of Host Isolate Aggressiveness and Factors Affecting Aetiology. Plant Pathol. 2010, 59, 1114–1120. [Google Scholar] [CrossRef]
- Fan, Y.; Zhang, W.; Kang, Y.; Shi, M.; Yang, X.; Yu, H.; Zhang, R.; Liu, Y.; Qin, S. Physiological and Dynamic Transcriptome Analysis of Two Potato Varieties Reveal Response of Lignin and MAPK Signal to Dry Rot Caused by Fusarium sulphureum. Sci. Hortic. 2021, 289, 110470. [Google Scholar] [CrossRef]
- Secor, G.A.; Gudmestad, N.C. Managing Fungal Diseases of Potato. Can. J. Plant Pathol. 1999, 21, 213–221. [Google Scholar] [CrossRef]
- Desjardins, A.E. Fusarium Mycotoxins: Chemistry, Genetics, and Biology; APS Press, American Phytopathological Society: St. Paul, MN, USA, 2006; ISBN 978-0-89054-335-1. [Google Scholar]
- Bojanowski, A.; Avis, T.J.; Pelletier, S.; Tweddell, R.J. Management of Potato Dry Rot. Postharvest Biol. Technol. 2013, 84, 99–109. [Google Scholar] [CrossRef]
- Xing-dong, L.; Hua-li, X. Antifungal Activity of the Essential Oil of Zanthoxylum bungeanum and Its Major Constituent on Fusarium sulphureum and Dry Rot of Potato Tubers. Phytoparasitica 2014, 42, 509–517. [Google Scholar] [CrossRef]
- Vatankhah, M.; Saberi Riseh, R.; Moradzadeh Eskandari, M.; Sedaghati, E.; Alaie, H.; Afzali, H. Biological Control of Fusarium Dry Rot of Potato Using Some Probiotic Bacteria. J. Agric. Sci. Technol. 2019, 21, 1301–1312. [Google Scholar]
- Xue, H.; Liu, Q.; Yang, Z. Pathogenicity, Mycotoxin Production, and Control of Potato Dry Rot Caused by Fusarium spp.: A Review. J. Fungi 2023, 9, 843. [Google Scholar] [CrossRef]
- Peters, J.C.; Lees, A.K.; Cullen, D.W.; Sullivan, L.; Stroud, G.P.; Cunnington, A.C. Characterization of Fusarium spp. Responsible for Causing Dry Rot of Potato in Great Britain. Plant Pathol. 2008, 57, 262–271. [Google Scholar] [CrossRef]
- Al-Mughrabi, K.I.; Coleman, W.K.; Vikram, A.; Poirier, R.; Jayasuriya, K.E. Effectiveness of Essential Oils and Their Combinations with Aluminum Starch Octenylsuccinate on Potato Storage Pathogens. J. Essent. Oil Bear. Plants 2013, 16, 23–31. [Google Scholar] [CrossRef]
- Bång, U. Influence of Seed Tuber Infestation, Chemical Seed Treatment, and Pre-Harvest Climate on Incidence of Gangrene and Dry Rot of Potato (Solanum tuberosum L.). Potato Res. 1992, 35, 3–15. [Google Scholar] [CrossRef]
- Ranganna, B.; Kushalappa, A.C.; Raghavan, G.S.V. Ultraviolet Irradiance to Control Dry Rot and Soft Rot of Potato in Storage. Can. J. Plant Pathol. 1997, 19, 30–35. [Google Scholar] [CrossRef]
- Hua-Li, X.; Yang, B.; Yuan-Yuan, Z.; Calderón-Urrea, A.; Hu-Jun, W.; Lu-Mei, P.; Yi, W.; Yong-Cai, L. Erratum to: Effects of Elicitors on Trichothecene Accumulation and Tri Genes Expression in Potato Tubers Inoculated with Fusarium sulphureum. Eur. J. Plant Pathol. 2017, 149, 239. [Google Scholar] [CrossRef]
- Li, Y.; Sun, X.; Bi, Y.; Ge, Y.; Wang, Y. Antifungal Activity of Chitosan on Fusarium sulphureum in Relation to Dry Rot of Potato Tuber. Agric. Sci. China 2009, 8, 597–604. [Google Scholar] [CrossRef]
- Yaganza, E.S.; Tweddell, R.J.; Arul, J. Postharvest Application of Organic and Inorganic Salts To Control Potato (Solanum tuberosum L.) Storage Soft Rot: Plant Tissue–Salt Physicochemical Interactions. J. Agric. Food Chem. 2014, 62, 9223–9231. [Google Scholar] [CrossRef]
- Aydin, M.H. Evaluation of Some Trichoderma Species in Biological Control of Potato Dry Rot Caused by Fusarium sambucinum Fuckel Isolates. Appl. Ecol. Environ. Res. 2019, 17, 533–546. [Google Scholar] [CrossRef]
- Wei, J.; Bi, Y.; Xue, H.; Wang, Y.; Zong, Y.; Prusky, D. Antifungal Activity of Cinnamaldehyde against Fusarium sambucinum Involves Inhibition of Ergosterol Biosynthesis. J. Appl. Microbiol. 2020, 129, 256–265. [Google Scholar] [CrossRef]
- Albuquerque, C.C.D.; Camara, T.R.; Mariano, R.D.L.R.; Willadino, L.; Marcelino Júnior, C.; Ulisses, C. Antimicrobial Action of the Essential Oil of Lippia Gracilis Schauer. Braz. Arch. Biol. Technol. 2006, 49, 527–535. [Google Scholar] [CrossRef]
- Bakkali, F.; Averbeck, S.; Averbeck, D.; Idaomar, M. Biological Effects of Essential Oils—A Review. Food Chem. Toxicol. 2008, 46, 446–475. [Google Scholar] [CrossRef]
- Baldim, I.; Tonani, L.; Von Zeska Kress, M.R.; Pereira Oliveira, W. Lippia sidoides Essential Oil Encapsulated in Lipid Nanosystem as an Anti-Candida Agent. Ind. Crops Prod. 2019, 127, 73–81. [Google Scholar] [CrossRef]
- Bergman, M.E.; Davis, B.; Phillips, M.A. Medically Useful Plant Terpenoids: Biosynthesis, Occurrence, and Mechanism of Action. Molecules 2019, 24, 3961. [Google Scholar] [CrossRef] [PubMed]
- Masotti, V.; Juteau, F.; Bessière, J.M.; Viano, J. Seasonal and Phenological Variations of the Essential Oil from the Narrow Endemic Species Artemisia molinieri and Its Biological Activities. J. Agric. Food Chem. 2003, 51, 7115–7121. [Google Scholar] [CrossRef]
- Mugao, L. Factors Influencing Yield, Chemical Composition and Efficacy of Essential Oils. Int. J. Multidiscip. Res. Growth Eval. 2024, 5, 169–178. [Google Scholar] [CrossRef]
- Angioni, A.; Barra, A.; Coroneo, V.; Dessi, S.; Cabras, P. Chemical Composition, Seasonal Variability, and Antifungal Activity of Lavandula stoechas L. ssp. Stoechas Essential Oils from Stem/Leaves and Flowers. J. Agric. Food Chem. 2006, 54, 4364–4370. [Google Scholar] [CrossRef]
- Masango, P. Cleaner Production of Essential Oils by Steam Distillation. J. Clean. Prod. 2005, 13, 833–839. [Google Scholar] [CrossRef]
- Bahrami, R.; Kocheili, F.; Ziaee, M. Fumigant Toxicity and Persistence of Essential Oils from Asafetida, Geranium, and Walnut on Adults of Rhyzopertha dominica (Col.: Bostrichidae). Toxin Rev. 2016, 35, 63–68. [Google Scholar] [CrossRef]
- Maes, C.; Bouquillon, S.; Fauconnier, M.-L. Encapsulation of Essential Oils for the Development of Biosourced Pesticides with Controlled Release: A Review. Molecules 2019, 24, 2539. [Google Scholar] [CrossRef]
- Sempere-Ferre, F.; Asamar, J.; Castell, V.; Roselló, J.; Santamarina, M.P. Evaluating the Antifungal Potential of Botanical Compounds to Control Botryotinia fuckeliana and Rhizoctonia solani. Molecules 2021, 26, 2472. [Google Scholar] [CrossRef]
- Caputo, L.; Reguilon, M.D.; Mińarro, J.; De Feo, V.; Rodriguez-Arias, M. Lavandula angustifolia Essential Oil and Linalool Counteract Social Aversion Induced by Social Defeat. Molecules 2018, 23, 2694. [Google Scholar] [CrossRef]
- Pavela, R.; Benelli, G. Essential Oils as Ecofriendly Biopesticides? Challenges and Constraints. Trends Plant Sci. 2016, 21, 1000–1007. [Google Scholar] [CrossRef] [PubMed]
- Morkeliūnė, A.; Rasiukevičiūtė, N.; Šernaitė, L.; Valiuškaitė, A. The Use of Essential Oils from Thyme, Sage and Peppermint against Colletotrichum acutatum. Plants 2021, 10, 114. [Google Scholar] [CrossRef]
- Coleman, W.K.; Lonergan, G.; Silk, P. Potato Sprout Growth Suppression by Menthone and Neomenthol, Volatile Oil Components of Minthostachys, Satureja, Bystropogon, and Mentha Species. Am. J. Pot. Res. 2001, 78, 345–354. [Google Scholar] [CrossRef]
- El Bous, M.; Soliman, W.; Ibrahim, M.; El Baz, H. In vitro Evaluation of Syzygium aromaticum L. Ethanol Extract as Biocontrol Agent against Postharvest Tomato and Potato Diseases. Egypt. J. Bot. 2018, 59, 81–94. [Google Scholar] [CrossRef]
- Manganyi, M.C.; Regnier, T.; Olivier, E.I. Antimicrobial Activities of Selected Essential Oils against Fusarium oxysporum Isolates and Their Biofilms. S. Afr. J. Bot. 2015, 99, 115–121. [Google Scholar] [CrossRef]
- Medjahed, I.M.; Benyelles, N.G.; Senouci, H.; Gaouar, M.Y. Individual and Combined Antifungal Activities of Artemisia herba alba and Ammoides verticillata Essential Oils against the Three Main Pathogenic Microorganisms of Potato. Comb. Chem. High Throughput Screen. 2023, 26, 1920–1928. [Google Scholar] [CrossRef]
- Kmoch, M.; Loubová, V.; Veselská, M.; Jílková, B.; Víchová, J. Antifungal Activity of Essential Oils on Helminthosporium solani Causing Potato Silver Scurf under In vitro and In vivo Conditions. Agriculture 2023, 14, 66. [Google Scholar] [CrossRef]
- Plodpai, P.; Chuenchitt, S.; Petcharat, V.; Chakthong, S.; Voravuthikunchai, S.P. Anti-Rhizoctonia solani Activity by Desmos chinensis Extracts and Its Mechanism of Action. Crop Prot. 2013, 43, 65–71. [Google Scholar] [CrossRef]
- Akosah, Y.A.; Kostennikova, Z.S.; Lutfullin, M.T.; Lutfullina, G.F.; Afordoanyi, D.M.; Vologin, S.G.; Mardanova, A.M. Induced Expression of Cyp51a and Hk1 Genes Associated with Penconazole and Fludioxonil Resistance in the Potato Pathogen Fusarium oxysporum. Microorganisms 2023, 11, 1257. [Google Scholar] [CrossRef]
- Matušinsky, P.; Maňasová, M.; Zouhar, M. Fungicidní Prostředek na Ochranu Rostlin na Základě Esenciálního oleje z Thymus vulgaris, Způsob jeho Výroby a Použití. Czech Patent CZ 308145 B6, 11 December 2020. [Google Scholar]
- Vidner, J.; Dobiáš, K.; Dědič, P.; Bareš, I.; Sehnalová, J. Klasifikátor Genus Solanum L. Genové Zdroje 1987, 31, 45. [Google Scholar]
- De Vincenzi, M.; Stammati, A.; De Vincenzi, A.; Silano, M. Constituents of Aromatic Plants: Carvacrol. Fitoterapia 2004, 75, 801–804. [Google Scholar] [CrossRef] [PubMed]
- Mączka, W.; Twardawska, M.; Grabarczyk, M.; Wińska, K. Carvacrol—A Natural Phenolic Compound with Antimicrobial Properties. Antibiotics 2023, 12, 824. [Google Scholar] [CrossRef]
- Escobar, A.; Pérez, M.; Romanelli, G.; Blustein, G. Thymol Bioactivity: A Review Focusing on Practical Applications. Arab. J. Chem. 2020, 13, 9243–9269. [Google Scholar] [CrossRef]
- Kamatou, G.P.P.; Vermaak, I.; Viljoen, A.M.; Lawrence, B.M. Menthol: A Simple Monoterpene with Remarkable Biological Properties. Phytochemistry 2013, 96, 15–25. [Google Scholar] [CrossRef]
- Malekmohammad, K.; Rafieian-Kopaei, M.; Sardari, S.; Sewell, R.D.E. Toxicological Effects of Mentha x Piperita (Peppermint): A Review. Toxin Rev. 2021, 40, 445–459. [Google Scholar] [CrossRef]
- Friedman, M. Chemistry, Antimicrobial Mechanisms, and Antibiotic Activities of Cinnamaldehyde against Pathogenic Bacteria in Animal Feeds and Human Foods. J. Agric. Food Chem. 2017, 65, 10406–10423. [Google Scholar] [CrossRef] [PubMed]
- Guzman, J. Natural Cinnamic Acids, Synthetic Derivatives and Hybrids with Antimicrobial Activity. Molecules 2014, 19, 19292–19349. [Google Scholar] [CrossRef]
- Oosterhaven, J. Different Aspects of S-Carvone, a Natural Potato Sprout Growth Inhibitor; Landbouwuniversiteit te Wageningen: Wageningen, The Netherlands, 1995; ISBN 978-90-5485-435-7. [Google Scholar]
- Gorris, L.G.M.; Oosterhaven, K.; Hartmans, K.J.; de Witte, Y.; Smid, E.J. Control of Fungal Storage Diseases of Potato by Use of Plant Essential Oil Components. In Brighton Crop Protection Conference, Pests and Diseases; British Crop Protection Council: Farnham, UK, 1994; pp. 307–312. [Google Scholar]
- Awadalla, O.A.; Abu El-Souod, S.M.; Assawah, S.M.W.; El-Debaky, S.A. Control of Dry and Soft Rot Disease of Potato Tubers Using Essential Oils, Fungicides and Antagonistic Fungi. Egypt. J. Exp. Biol. (Bot.) 2008, 4, 1–11. [Google Scholar]
- Rai; Qureshi, S.; Pandey, A.K. In vitro Susceptibility of Opportunistic Fusarium spp. to Essential Oils. Mycoses 1999, 42, 97–101. [Google Scholar] [CrossRef]
- Bång, U. Screening of Natural Plant Volatiles to Control the Potato (Solanum tuberosum) Pathogens Helminthosporium solani, Fusarium solani, Phoma foveata and Rhizoctonia solani. Potato Res. 2007, 50, 185–203. [Google Scholar] [CrossRef]
- Bounar, R.; Krimat, S.; Boureghda, H.; Dob, T. Chemical Analyses, Antioxidant and Antifungal Effects of Oregano and Thyme Essential Oils Alone or in Combination against Selected Fusarium Species. Int. Food Res. J. 2020, 27, 66–77. [Google Scholar]
- Hartmans, K.J.; Diepenhorst, P.; Bakker, W.; Gorris, L.G.M. The Use of Carvone in Agriculture: Sprout Suppression of Potatoes and Antifungal Activity against Potato Tuber and Other Plant Diseases. Ind. Crops Prod. 1995, 4, 3–13. [Google Scholar] [CrossRef]
- Slavov, S.; Nikolova, M. Origanum vulgare ssp. hirtum Essential Oil as Inhibitors of Fusarium Dry Rot of Potato. Biol. Life Sci. Forum 2021, 3, 40. [Google Scholar] [CrossRef]
- Krzyśko-Łupicka, T.; Mahdi Oraibi, S.; Kurp, E.; Walkowiak, W. A Possible Use of Selected Essential Oils and Citrosept to Inhibit the Growth of Fusarium solani Mart. (Sacc.). Adv. Microbiol. 2016, 6, 1159–1165. [Google Scholar] [CrossRef]
- Grudzińska, M.; Czerko, Z.; Borowska-Komenda, M. Changes of Organoleptic Quality in Potato Tubers after Application of Natural Sprout Inhibitors. Agric. Eng. 2016, 20, 35–43. [Google Scholar] [CrossRef][Green Version]
- Kalt, W.; Prange, R.K.; Daniels-Lake, B.J.; Walsh, J.; Dean, P.; Coffin, R. Alternative Compounds for the Maintenance of Processing Quality of Stored Potatoes (Solanum tuberosum). J. Food Process. Preserv. 1999, 23, 71–81. [Google Scholar] [CrossRef]
- Čížková, H.; Sevcik, R.; Vacek, J. Caraway Essential Oil as Potential Inhibitor of Potato Sprouting. Rostl. Vyrob. 2000, 46, 501–507. [Google Scholar]
- Gómez-Castillo, D.; Cruz, E.; Iguaz, A.; Arroqui, C.; Vírseda, P. Effects of Essential Oils on Sprout Suppression and Quality of Potato Cultivars. Postharvest Biol. Technol. 2013, 82, 15–21. [Google Scholar] [CrossRef]
- Şanlı, A.; Karadoğan, T. Carvone Containing Essential Oils as Sprout Suppressants in Potato (Solanum tuberosum L.) Tubers at Different Storage Temperatures. Potato Res. 2019, 62, 345–360. [Google Scholar] [CrossRef]
- Weiss, J.; Scherze, I.; Muschiolik, G. Polysaccharide Gel with Multiple Emulsion. Food Hydrocoll. 2005, 19, 605–615. [Google Scholar] [CrossRef]
- Ghosh, V.; Mukherjee, A.; Chandrasekaran, N. Ultrasonic Emulsification of Food-Grade Nanoemulsion Formulation and Evaluation of Its Bactericidal Activity. Ultrason. Sonochemistry 2013, 20, 338–344. [Google Scholar] [CrossRef] [PubMed]
- Pasukamonset, P.; Kwon, O.; Adisakwattana, S. Alginate-Based Encapsulation of Polyphenols from Clitoria Ternatea Petal Flower Extract Enhances Stability and Biological Activity under Simulated Gastrointestinal Conditions. Food Hydrocoll. 2016, 61, 772–779. [Google Scholar] [CrossRef]
- Giunti, G.; Campolo, O.; Laudani, F.; Zappalà, L.; Palmeri, V. Bioactivity of Essential Oil-Based Nano-Biopesticides toward Rhyzopertha dominica (Coleoptera: Bostrichidae). Ind. Crops Prod. 2021, 162, 113257. [Google Scholar] [CrossRef]
- Campolo, O.; Giunti, G.; Russo, A.; Palmeri, V.; Zappalà, L. Essential Oils in Stored Product Insect Pest Control. J. Food Qual. 2018, 2018, 6906105. [Google Scholar] [CrossRef]
- Nedovic, V.; Kalusevic, A.; Manojlovic, V.; Levic, S.; Bugarski, B. An Overview of Encapsulation Technologies for Food Applications. Procedia Food Sci. 2011, 1, 1806–1815. [Google Scholar] [CrossRef]
- Avila Gandra, E.; Radünz, M.; Helbig, E.; Dellinghausen Borges, C.; Kuka Valente Gandra, T. A Mini-Review on Encapsulation of Essential Oils. J. Anal. Pharm. Res. 2018, 7, 00205. [Google Scholar] [CrossRef]
- Mishra, M. (Ed.) Handbook of Encapsulation and Controlled Release; CRC Press: Boca Raton, FL, USA, 2015; ISBN 978-0-429-18347-8. [Google Scholar]
- Tiwari, S.; Singh, B.K.; Dubey, N.K. Encapsulation of Essential Oils—A Booster to Enhance Their Bio-Efficacy as Botanical Preservatives. J. Sci. Res. 2020, 64, 175–178. [Google Scholar] [CrossRef]
- Yuan, C.; Wang, Y.; Liu, Y.; Cui, B. Physicochemical Characterization and Antibacterial Activity Assessment of Lavender Essential Oil Encapsulated in Hydroxypropyl-Beta-Cyclodextrin. Ind. Crops Prod. 2019, 130, 104–110. [Google Scholar] [CrossRef]

| EO Component | Concentration of EO Component (µL/L) | |||||
|---|---|---|---|---|---|---|
| 0 | 100 | 200 | 400 | 800 | 1600 | |
| (R)-(+)-limonene | 0 | 0 | 2.22 lm | 12.96 hijk | 15.56 hij | 29.26 g |
| α-pinene | 0 | 0 | 0 | 6.32 jklm | 22.46 gh | 41.05 f |
| D-carvone | 0 | 9.82 ijklm | 66.32 de | 92.63 ab | 100 a | 100 a |
| carvacrol | 0 | 92.59 ab | 100 a | 100 a | 100 a | 100 a |
| eucalyptol | 0 | 0 | 0 | 10.37 ijkl | 69.26 de | 91.11 ab |
| cinnamaldehyde | 0 | 16.67 hi | 60.00 e | 100 a | 100 a | 100 a |
| L-linalool | 0 | 22.50 gh | 41.25 f | 75.00 cd | 100 a | 100 a |
| L-menthone | 0 | 5.19 klm | 39.63 f | 83.33 bc | 100 a | 100 a |
| L-menthol | 0 | 42.59 f | 82.96 bc | 100 a | 100 a | 100 a |
| thymol | 0 | 46.25 f | 100 a | 100 a | 100 a | 100 a |
| EO Component | IC50 (µL/L) | MIC (µL/L) | MFC (µL/L) |
|---|---|---|---|
| (R)-(+)-limonene | 2800 | 5600 | 5600 |
| α-pinene | 1900 | 3800 | 3900 |
| D-carvone | 210 | 420 | 900 |
| carvacrol | 60 | 120 | 150 |
| eucalyptol | 670 | 1340 | 1600 |
| cinnamaldehyde | 180 | 360 | 400 |
| L-linalool | 250 | 500 | 600 |
| L-menthone | 270 | 540 | 600 |
| L-menthol | 150 | 300 | 900 |
| thymol | 100 | 200 | 250 |
| EO Component | Fumigation | Dressing |
|---|---|---|
| Carvacrol | 40.03 | 81.44 |
| Cinnamaldehyde | 69.63 | 56.07 |
| Thymol | 57.31 | 61.16 |
| Variant | Odor | Taste | Flesh Firmness and Cooking Behavior | |
|---|---|---|---|---|
| Fumigation | carvacrol | 6 | 21 | 14 |
| cinnamaldehyde | 7 | 22 | 13 | |
| thymol | 7 | 22 | 13 | |
| control | 7 | 25 | 13 | |
| Dressing | carvacrol | 3 (odor of EO comp.) | 3 (taste of EO comp.) | 12 |
| cinnamaldehyde | 4 (odor of EO comp.) | 5 (taste of EO comp.) | 13 | |
| thymol | 3 (odor of EO comp.) | 8 (taste of EO comp.) | 13 | |
| control | 8 | 27 | 13 | |
Disclaimer/Publisher’s Note: The statements, opinions and data contained in all publications are solely those of the individual author(s) and contributor(s) and not of MDPI and/or the editor(s). MDPI and/or the editor(s) disclaim responsibility for any injury to people or property resulting from any ideas, methods, instructions or products referred to in the content. |
© 2025 by the authors. Licensee MDPI, Basel, Switzerland. This article is an open access article distributed under the terms and conditions of the Creative Commons Attribution (CC BY) license (https://creativecommons.org/licenses/by/4.0/).
Share and Cite
Kmoch, M.; Loubová, V.; Švecová, R.; Jílková, B. Effect of Essential Oil Components on the Growth Inhibition of Fusarium solani var. coeruleum During Potato Storage. Agronomy 2025, 15, 1126. https://doi.org/10.3390/agronomy15051126
Kmoch M, Loubová V, Švecová R, Jílková B. Effect of Essential Oil Components on the Growth Inhibition of Fusarium solani var. coeruleum During Potato Storage. Agronomy. 2025; 15(5):1126. https://doi.org/10.3390/agronomy15051126
Chicago/Turabian StyleKmoch, Martin, Věra Loubová, Renata Švecová, and Barbora Jílková. 2025. "Effect of Essential Oil Components on the Growth Inhibition of Fusarium solani var. coeruleum During Potato Storage" Agronomy 15, no. 5: 1126. https://doi.org/10.3390/agronomy15051126
APA StyleKmoch, M., Loubová, V., Švecová, R., & Jílková, B. (2025). Effect of Essential Oil Components on the Growth Inhibition of Fusarium solani var. coeruleum During Potato Storage. Agronomy, 15(5), 1126. https://doi.org/10.3390/agronomy15051126

